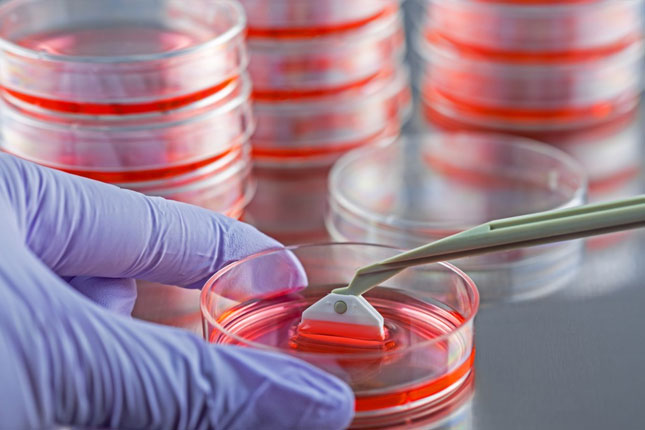
Istrči trku humanosti, upiši se u Registar dobrovoljnih davalaca matičnih ćelija hematopoeze!

Istrči trku humanosti, upiši se u Registar dobrovoljnih davalaca matičnih ćelija hematopoeze!

U subotu, od 16h na Trgu slobode, u okviru "Takmičarskog sajma", kao i na dan održavanja trke, učesnici polumaratona, kao i svi zainteresovani sugrađani imaće priliku da se informišu o značaju postojanja nesrodnih davalaca u Registru, kao i da se prijave u ovaj Registar. Ova akcija podržana je od strane sportskog udruženja "Horizont" koje je i organizator 5. Subotičkog polumaratona.
PROCEDURA PRIJAVE U REGISTAR: Registru mogu pristupiti zdrave osobe između 18 i 45 godina, koje ne boluju od teških oboljenja srca, pluća i bubrega, odnosno od malignih i autoimunih oboljenja. Prilikom registracije popunjava se kratak formular, a potom se daje uzorak krvi iz vene. Nakon toga, na kućnu adresu, prijavljenoj osobi stiže personalizovana kartica koja potvrđuje da je upisana u Registar i pod kojim brojem. Kada se jednom prijavi, podaci o toj osobi ostaju u Registru dok ne napuni 60 godina.
- Sam čin pristupanja Registru iziskuje svega 5 minuta vremena i jednu malu epruvetu krvi uzetu iz periferne vene. Čitava procedura svakako neće umanjiti fizičku spremnost trkača, naprotiv, može samo pojačati takmičarski duh saznanjem da možete nekome doslovno spasiti život. Pozivam sve Subotičane da dođu u subotu i nedelju na Trg slobode, daju jednu epruvetu krvi, upišu se u Registar i pokažu svoju humanu i ljudsku stranu - poručuje dr Glorija Blagojević iz Instituta za transfuziju krvi Srbije.

DAVANJE MATIČNIH ĆELIJA: Davanje matičnih ćelija potpuno je bezbedno i bezbolno. Ukoliko se ustanovi da je davalac podudaran sa nekim pacijentom, poziva se u dalju proceduru. Prijavljivanje u Registar ne obavezuje i samo davanje matičnih ćelija hematopoeze sve se svodi na princip dobre volje i želju da se pomogne. Matične ćelije se mogu prikupiti na dva načina, iz bedrene kosti i iz periferne krvi, a način na koji će donirati matične ćelije bira isključivo davalac. Pre samog doniranja matičnih ćelija davalac prolazi kroz opsežan lekarski pregled. Danas se matične ćelije najčešće prikupljaju iz periferne krvi, procedura je komforna za davaoca, traje par sati i vrlo je slična davanju krvi.
Često je transplantacija matičnih ćelija jedini put ka izlečenju bolesti kao što su akutna leukemija, aplastična anemija, imune deficijencije, urođeni poremećaji metabolizma i drugih, inače većina obolelih neće preživeti.
- Samo 30 odsto bolesnika ima podudarnog davaoca u okviru svoje porodice, zato nesrodni davaoci preostaju kao jedina mogućnost. Na žalost, za jedan broj obolelih davalac se nikada ne pronađe, pa samim tim šanse za njihovo preživljavanje ne postoje - navodi dr Blagojević i dodaje da iako je Srbija deo Svetskog registra, veća je verovatnoća da će oboleli imati kompatibilnog davaoca na istom geografskom području - Upravo zbog toga nam je neophodan jak nacionalni registar, a to znači da mora brojati najmanje 100 hiljada prijavljenih davalaca. Trenutno ih ima oko 11.500.
Zbog nedovoljnog broja prijavljenih dobrovoljnih davalaca matičnih ćelija hematopoeze, pacijenti iz Srbije prinuđeni su da se oslanjaju na Svetski registar i humane građane drugih država, pre svega iz Nemačke, Turske, Poljske, Izraela, koji doniraju matične ćelije našim obolelim sugrađanima.
Zbog nedovoljnog broja prijavljenih dobrovoljnih davalaca matičnih ćelija hematopoeze, pacijenti iz Srbije prinuđeni su da se oslanjaju na Svetski registar i humane građane drugih država, pre svega iz Nemačke, Turske, Poljske, Izraela, koji doniraju matične ćelije našim obolelim sugrađanima.
- Međutim, traženje nesrodnog davaoca u inostranstvu, preko Svetskog registra, dodatno usporava proces izlečenja, čime se i umanjuju šansa za preživljavanje pacijenta - završava sagovornica.





Komentari